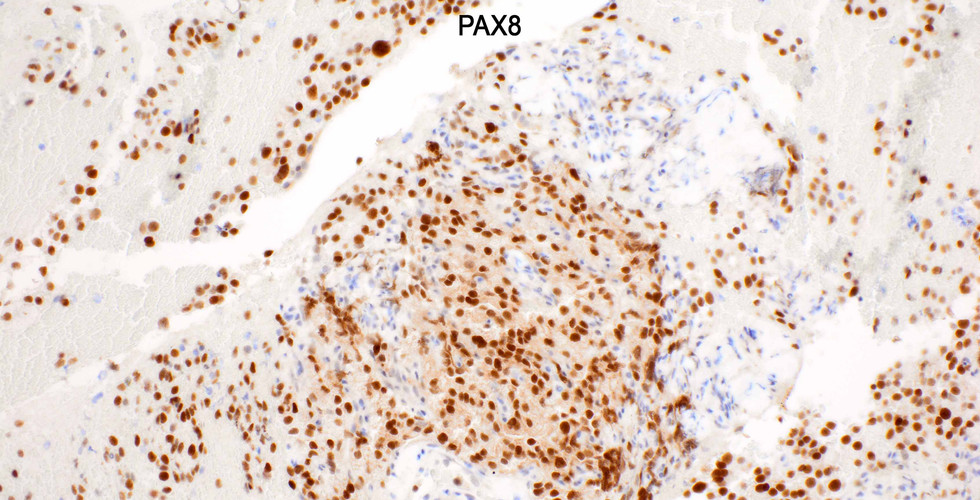

Case of the Week
- Elizabeth Montgomery, MD
- Jul 11, 2024
- 1 min read
Metastatic renal cell carcinoma to the pancreas. At first glance, the malignant cells display morphologic overlap with histiocytes.
Case provided by Dr. Elizabeth Montgomery, Clinical Professor, Vice Chair of Faculty Development & Mentoring, Director of Surgical Pathology Fellowship Training Program, Co-Director, Pathology Reference Services, and Editor-In-Chief at Innovative Science Press.
You can check out our titles at:
1-703-350-4308/703-340-3198

Comments